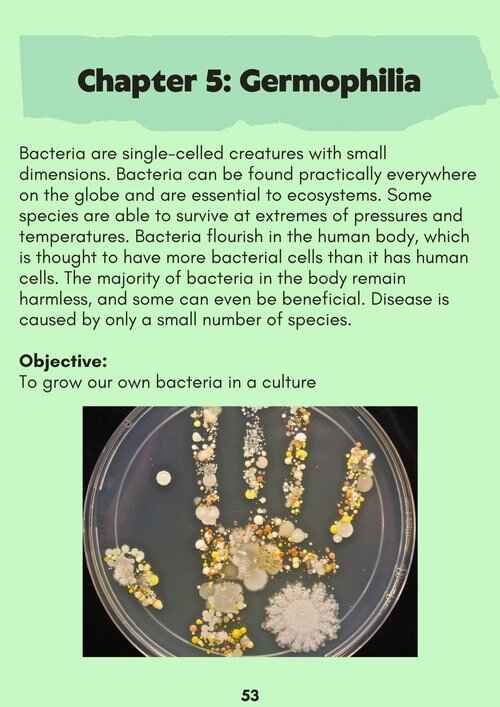
Image

LittleLab Supplementary Curriculum
An extensive, supplementary curriculum designed to add to students’ knowledge of concepts taught in the CBSE curriculum, such centripetal force and trigonometric derivatives, through exciting, practical, and low-equipment activities. Modules include experiments in Mathematics, Physics, Chemistry, Biology, and Environmental Science.